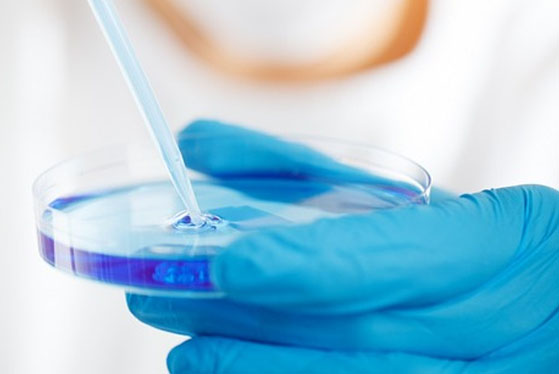

OFFERING A WIDE RANGE OF DIAGNOSTIC SERVICES
We provide a wide range of diagnostic tests, physiotherapy treatment and specialised dietic consultation, designed to meet the special needs of infants, children and teens – from simple blood draws and comprehensive medical imaging to the most complex genetic testing. Our facilities feature state-of-the-art technologies, including the most advanced diagnostic services available in the region for Pediatric and Neonatal patients. For every diagnostic service we provide, our focus is on performing the safest procedure, reducing stress to the child and delivering results quickly to the healthcare provider who ordered the test.
Mr. Sankar is no more working with us. We therefore would like to inform to public at large that, anyone doing any clinical / technical / financial business, with him assuming him to be the representative/staff of "hellobookmylab" would be doing so at their own risk and "hellobookmylab" will not be held responsible for any loss arising thereof.

hellobookmylab is to provide the best &consistent performance of routine and advance diagnostic and pathology testing services, clinical trials and home collection services at the fairest price to the patient and to strive towards excellence in every situation to uphold the integrity our services

On the other hand we denounce with righteous indignation.
hellobookmylab runs strict internal quality controls on a daily basis and regularly participates in external proficiency testing programme from nodal institutes of repute, in order to provide reliable, accurate and quality test results.

On the other hand we denounce with righteous indignation and dislike men who are so beguiled and demoralized by the pleasure of the desire that they cannot foresee.
On the other hand we denounce with righteous indignation and dislike men who are so beguiled and demoralized by the pleasure of the desire that they cannot foresee.

hellobookmylab operate within the regulatory requirements and/or accreditation standards of the following organizations:
S.C.O. No.: 14, First Floor,
Western Homes, Jhungia Road, Kharar: 140301
Toll Free No. 1800 – 890 -11- 44
Email:connect@hellobookmylab.com
Monday to Sunday:
06:00 AM to 09:00 PM